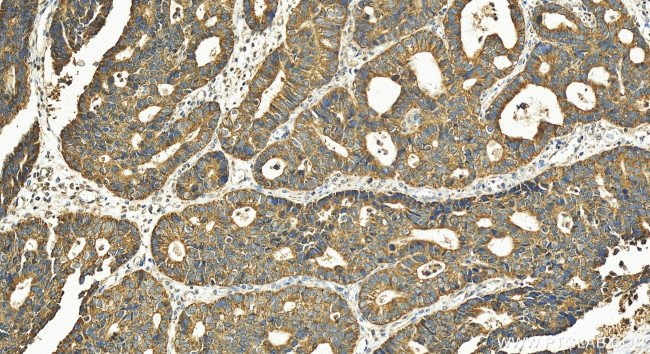
PGT Antibody in Immunohistochemistry (Paraffin) (IHC (P))

Search
Proteintech
PGT Polyclonal Antibody
{{$productOrderCtrl.translations['antibody.pdp.commerceCard.promotion.promotions']}}
{{$productOrderCtrl.translations['antibody.pdp.commerceCard.promotion.viewpromo']}}
{{$productOrderCtrl.translations['antibody.pdp.commerceCard.promotion.promocode']}}: {{promo.promoCode}} {{promo.promoTitle}} {{promo.promoDescription}}. {{$productOrderCtrl.translations['antibody.pdp.commerceCard.promotion.learnmore']}}
产品信息
30434-1-AP
种属反应
宿主/亚型
分类
类型
抗原
偶联物
形式
浓度
规格
纯化类型
保存液
内含物
保存条件
运输条件
产品详细信息
Immunogen sequence: FFMGCSTPTV AEVYPPSTSS SIHPQSPACR RDCSCPDSIF HPVCGDNGIE YLSPCHAGCS NINMSSATSK QLIYLNCSCV TGGSASAKTG SCPVPCAHFL LPA
靶标信息
Prostaglandin transporter (PGT), also known as SLCO2A1, has been identified as a functional prostaglandin (PG) carrier that mediates either the release of newly-synthesized PGs by cells and/or the uptake of PGs prior to intracellular oxidation. Northern blot analysis revealed that PGT mRNA has broad tissue distribution, suggesting its role in the transport and/ or metabolic clearance of PG in diverse tissues (8787677).
仅用于科研。不用于诊断过程。未经明确授权不得转售。
篇参考文献 (0)
生物信息学
蛋白别名: matrin F/G 1; OATP2A1; PGT; PHOAR2; Prostaglandin transporter; SLC21A2; SLCO2A1; solute carrier family 21 (prostaglandin transporter), member 2; Solute carrier family 21 member 2; Solute carrier organic anion transporter family member 2A1; unnamed protein product
基因别名: 2310021C19Rik; MATR1; mPgt; OATP2A1; PGT; PHOAD; PHOAR2; SLC21A2; SLCO2A1
UniProt ID: (Human) Q92959, (Mouse) Q9EPT5
Entrez Gene ID: (Human) 6578, (Mouse) 24059